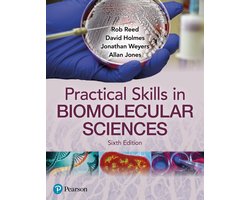
Omslag van Practical Skills in Biomolecular Science

Boeken zoals: Chemical and Engineering Thermodynamics
Tips voor lezers van Stanley I. Sandler
Heb je Chemical and Engineering Thermodynamics gelezen? Of ben je fan van de boeken van Stanley I. Sandler? Dan vind je hieronder een aantal leestips die ook werden gezocht door lezers van 'Chemical and Engineering Thermodynamics'.

Practical Skills in Biomolecular Science 5th edn
ISBN 9781292100739
If you are studying the biomolecular sciences - including biochemistry, biomedical sciences, biotechnology ...
€ 22.90

The Repair of Vehicle Bodies, 6th ed
ISBN 9780415534451
This book covers the principles and techniques that will help you develop the skills needed to carry out ...
€ 34.55

Principles Of Engineering Thermodynamics
ISBN 9780470918012
This leading text in the field maintains its engaging, readable style while presenting a broader range of ...
€ 25.60

Chemistry, Global Edition
ISBN 9781292092751
For two-semester general chemistry courses (science majors). Make critical connections in chemistry clear and ...
€ 25.30
Practical Skills in Biomolecular Science
ISBN 9781292397085
“A very impressive and in-depth book, every practical skill is covered. The study exercises are excellent ...
€ 62.28

Biology
ISBN 9781119645023
THE MOST PRACTICAL, EASY-TO-USE GUIDE TO LEARN BIOLOGY AT YOUR OWN PACE Biology: A Self-Teaching Guide helps ...
€ 24.97
Chemical and Engineering Thermodynamics
